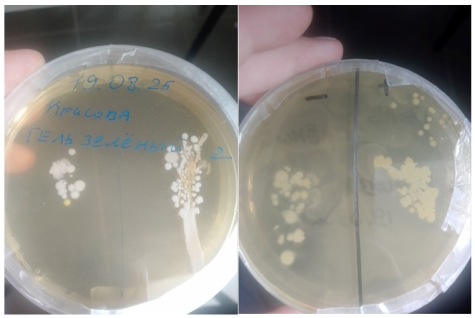
Чашки Петри с выросшими колониями

Люди в процессе своей жизнедеятельности постоянно контактируют с миром при помощи рук, таким образом, на руках, помимо уже находившихся там неопасных для человека бактерий, скапливаются и другие, которые могут быть патогенными [1]. Для того чтобы обезопасить себя, человек обрабатывает руки. Существует множество способ обработки рук, таких как водопроводная вода, твёрдое мыло, жидкое мыло, влажные салфетки, гели для обработки, антисептический гель для обработки, спирт 97 %. Каждый из них имеет свою эффективность, оцениваемую в исследовании. Также на качество обработки рук влияет длительность обработки рук, количество средства обработки рук и тщательность обработки рук [2].
Цель работы: оценить степень эффективности различных способов обработки рук.
Задачи исследования:
- Провести обработку рук различными способами: водопроводная вода, твёрдое мыло, жидкое мыло, влажные салфетки, два вида гелей для обработки, антисептический гель для обработки, спирт 97 %.
- Произвести посевы с рук до и после их обработки в стерильные чашки Петри с питательным агаром.
- Выполнить подсчет выросших на чашках колоний, определить общее наиболее эффективный способ обработки рук и выразить результат в рекомендациях.
- Определить тип окраски бактерии по Грамму.
Материалы и
методы:
пробы отбирались с рук, до обработки и после обработки рук. Руки обрабатывались несколькими разными методами: водопроводная вода, твёрдое мыло, жидкое мыло, влажные салфетки, два вида гелей для обработки, антисептический гель для обработки, спирт 97 % [6]. Для этого сначала стерильная чашка Петри разделялась пополам маркерной чертой, одна сторона отмечалась как до обработки, а другая после обработки. После этого к стороне без обработки прикасались необработанным пальцем. Затем руки обрабатывались, соответствующим средством и прикасались пальцем к стороне после обработки [3]. Чашка Петри закрывалась и герметизировалась лентой ParaFilm, чашка отправлялась в термостат на 48 часов при температуре 37

LG = log10(КОЕ_контроль ["-"]) — log10(КОЕ_опыт ["+"])
Если КОЕ_опыт = 0, для расчета используется значение 1. Интерпретация: Высокое значение LG для конкретного типа колоний означает, что средство эффективно против данной микрофлоры.
После, чашки вскрывались внутри ламинарного бокса, чтобы создать стерильные условия и обезопасить окружающих, готовили мазки на предметных стеклах. Определение типа бактерий грамположительные или грамотрицательные проводилось методом окраски по Граму. Затем исследовали приготовленные препараты с помощью микроскопа Zeiss AXIO Imager.Z с камерой AxioCam MRc 5 (FireWire, 5MP, 2/3"), сделали снимки колоний разных типов.
Результаты:
Таблица 1
Расчеты соотношения количества колоний до и после обработки
|
Средство |
Общее (LG ± SEM) |
Тип 1 (LG ± SEM) |
Тип 2 (LG ± SEM) |
Тип 3 (LG ± SEM) |
|
Спирт |
1.73 ± 0.19 |
1.84 ± 0.22 |
1.55 ± 0.25 |
N/A |
|
Антисептик |
0.15 ± 0.09 |
0.20 ± 0.13 |
-0.05 ± 0.12 |
0.70 ± 0.70 |
|
Жидкое мыло |
0.87 ± 0.39 |
1.30 ± 0.65 |
0.00 ± 0.00 |
0.00 ± 0.00 |
|
Твердое мыло |
0.17 ± 0.11 |
0.10 ± 0.10 |
0.24 ± 0.14 |
0.20 ± 0.20 |
|
Вода |
0.25 ± 0.17 |
0.00 ± 0.00 |
0.48 ± 0.48 |
N/A |
|
Гель желтый |
1.19 ± 0.49 |
1.46 ± 0.58 |
0.85 ± 0.49 |
0.00 ± 0.00 |
|
Гель зеленый |
0.17 ± 0.07 |
0.21 ± 0.08 |
0.13 ± 0.09 |
0.15 ± 0.15 |
|
Салфетки |
0.21 ± 0.16 |
0.19 ± 0.16 |
0.24 ± 0.18 |
0.20 ± 0.20 |
Примечание: N/A — недостаточно данных для расчета. Тип 1 — белые круглые колонии, Тип 2 — желтые круглые, Тип 3 — белые разросшиеся. Отрицательное значение указывает на стимуляцию роста микроорганизмов.
Методология расчета:
Анализ по типам колоний: для каждого типа колоний (1, 2, 3) и для общего количества («общее») рассчитали логарифмическое снижение (LG) для каждой повторности. LG = log10(КОЕ_контроль ["-"]) — log10(КОЕ_опыт ["+"])
Если КОЕ_опыт = 0, для расчета используется значение 1. Для каждого способа обработки рассчитали среднее значение LG и стандартную ошибку среднего (SEM) отдельно для общего снижения и для снижения по каждому типу колоний. Высокое значение LG для конкретного типа колоний означает, что средство эффективно против данной микрофлоры [5].
Рис. 1. Чашки Петри с выросшими колониями
Детальный анализ по способам обработки:
1. Спирт. Общее снижение (LG): 1.73 ± 0.19 (Умеренная эффективность). Спирт показал хорошую и равномерную эффективность против основных представленных типов микроорганизмов (1 и 2). Это надежное средство широкого спектра действия.
По типам: Тип 1 (белые круглые): LG = 1.84 (Эффективен)
Тип 2 (желтые круглые): LG = 1.55 (Эффективен)
Тип 3 (белые разросшиеся): недостаточно данных для расчета, но в контроле их было мало.
2. Антисептик. Общее снижение (LG): 0.15 ± 0.09 (Неэффективен). Средство не только не работает, но и может стимулировать рост некоторых микроорганизмов (тип 2). Абсолютно непригодно к использованию.
По типам: Тип 1: LG = 0.20 (Неэффективен). Тип 2: LG = -0.05 (Стимулирует рост! В опытной группе рост больше, чем в контрольной). Тип 3: LG = 0.70 (Слабая эффективность только против этого типа).
3. Жидкое мыло. Общее снижение (LG): 0.87 ± 0.39 (Недостаточная эффективность). Мыло эффективно смывает преимущественно микроорганизмы типа 1, но совершенно не справляется с типами 2 и 3. Это подтверждает его роль как механического средства для удаления части микробной биоты, но не всего микробного сообщества. По типам: Тип 1: LG = 1.30 (Умеренная эффективность). Тип 2: LG = 0.00 (Полное отсутствие эффекта). Тип 3: LG = 0.00 (Полное отсутствие эффекта).
4. Твердое мыло. Общее снижение (LG): 0.17 ± 0.11 (Неэффективно) Эффективность против всех типов микроорганизмов крайне низка. Низкие показатели LG и риск контаминации самого куска мыла делают его использование недопустимым. По типам: Тип 1: LG = 0.10 (Неэффективно). Тип 2: LG = 0.24 (Слабая эффективность). Тип 3: LG = 0.20 (Слабая эффективность).
5. Вода. Общее снижение (LG): 0.25 ± 0.17 (Неэффективна). Вода имеет минимальный эффект, в основном смывая некоторую часть микрофлоры типа 2. Не является методом дезинфекции. По типам: Тип 1: LG = 0.00 (Неэффективна). Тип 2: LG = 0.48 (Слабая эффективность). Тип 3: Эффективность не оценивается (везде 0).
6. Гель желтый. Общее снижение (LG): 1.19 ± 0.49 (Нестабильная эффективность). Гель показывает избирательную эффективность. Он хорошо работает против типа 1, средне — против типа 2 и не работает против типа 3. Нестабильность общих результатов может быть связана с разным соотношением этих типов микробов в разных пробах. По типам: Тип 1: LG = 1.46 (Эффективен). Тип 2: LG = 0.85 (Слабая эффективность). Тип 3: LG = 0.00 (Неэффективен).
7. Зеленый гель. Общее снижение (LG): 0.17 ± 0.07 (Неэффективен) — полное отсутствие значимой эффективности против всех трех типов микроорганизмов. По типам: Тип 1: LG = 0.21 (Неэффективен). Тип 2: LG = 0.13 (Неэффективен). Тип 3: LG = 0.15 (Неэффективен).
8. Салфетки. Общее снижение (LG): 0.21 ± 0.16 (Неэффективны) — равномерно низкая эффективность против всех типов микробов. Механическое удаление с помощью этих салфеток недостаточно. По типам: Тип 1: LG = 0.19 (Неэффективны). Тип 2: LG = 0.24 (Неэффективны). Тип 3: LG = 0.20 (Неэффективны).

Рис. 2. Подготовка мазков для препаратов с отбором основных типов колоний
Результаты микроскопирования: для идентификации колоний делали препараты с получившимися типами колоний методом окраски по Граму. Колонии 1, 3, 4 оказались грамположительными. Колонии 2 — грамотрицательные. 1, 2, 4 типы оказались кокками и стрептококками, 3 тип — палочки (бациллы).

Рис. 3. Окраска мазков методом Грама

Рис. 4. Полученные колонии: а — Тип 1; б — Тип 2; в — Тип 3; г — Тип 4
Выводы: По результатам наших исследований оказалось, что спирт — единственное средство широкого спектра действия, эффективное против основных выявленных типов микроорганизмов. Средства, отличившиеся селективной эффективностью (жидкое мыло, жёлтый гель) показали положительные результаты только против определённых типов микробов (тип 1), но были бесполезны против других (типы 2 и 3). Это делает их ненадёжными для полной дезинфекции. Полную неэффективностьпоказали такие средства как: антисептик, твёрдое мыло, зелёный гель, салфетки и вода, онине должны использоваться для обеззараживания рук. Результаты по твёрдому мылу и антисептику (стимуляция роста) указывают на возможные проблемы с их чистотой или составом. Возможной причиной такого результата также может являться то, что испытуемый недостаточно правильно проводил обработку рук, необходимы дополнительные исследования на это. Колонии 1, 3, 4 оказались грамположительными. Колонии 2 — грамотрицательные. 1, 2, 4 типы оказались кокками и стрептококками, 3 тип — палочки (бациллы).
Благодарности. Исследования проведены на базе Алтайского государственного университета в рамках школьного научного лагеря BioCamp. Благодарим за помощь в исследовании: Ковальчук Ольгу Евгеньевну, Красильникова Ивана Андреевича, Красову Анастасию Валерьевну, Овчаренко Викторию Дмитриевну, Шевченко Константина Игоревича.
Литература:
- Кальченко Е. И. Гигиеническое обучение и воспитание школьников — М.: Просвещение, 1998. — 158 с.
- Камышева К. С. Основы микробиологии и иммунологии / К. С. Камышева. — Ростов-на-Дону: Феникс, 2018. — 382 с.
- Микрофлора кожи [Электронный ресурс]. — Режим доступа: http://медпортал.com/gigienasanepidkontrol_733/mikroflora-koji-49898.html (дата обращения: 19.08.2025).
- Пробактерии [Электронный ресурс]. — Режим доступа: http://probakterii.ru/prokariotes/for-human/bakterii-na-rukah.html (дата обращения: 19.08.2025).
- Рост, размножение и жизнеспособность микроорганизмов в искусственной и естественной среде обитания [Электронный ресурс] // Справочник по микробиологии. — Режим доступа: https://petritest.ru/sprav/labinskaya-obshchaya-i-sanitarnaya-mikrobiologiya/9–2-rost-razmnozhenie-i-zhiznesposobnost-mikroorganizmov-v-iskusstvennoj-i-estestvennoj-srede-obitaniya (дата обращения: 21.08.2025).
- Сендик З. А., Рожкова Ю. В. Сравнительный анализ эффективности разных способов обработки кожи рук // Вестник Башкирского государственного педагогического университета им. М. Акмуллы. 2020. № S1 (54).
- Черкес Ф. К. Микробиология — М.: Медицина, 1986. — 512 с.
- Шлегель Г. Х. Общая микробиология — М.: Мир, 1987. — 566 с.

